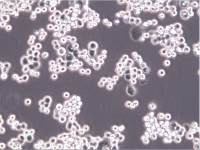
MDA-MB-453细胞、MDA-MB-453细胞、MDA-MB-453细胞

相关产品推荐更多 >
万千商家帮你免费找货
0 人在求购买到急需产品
- 详细信息
- 文献和实验
- 技术资料
- 英文名:
SK-N-MC
- 库存:
大量库存
- 供应商:
盖宁生物
- 肿瘤类型:
详询
- 细胞类型:
正常细胞/癌细胞
- ATCC Number:
详询
- 品系:
详询
- 组织来源:
详见说明
- 相关疾病:
详询
- 物种来源:
人源
- 免疫类型:
详询
- 细胞形态:
上皮细胞样
- 是否是肿瘤细胞:
是
- 器官来源:
详询人员
- 运输方式:
快递托运
- 年限:
永久
- 生长状态:
优良
特别提醒:该产品仅限于实验室科学研究使用,不得用于其他用途
提供STR鉴定报告

PubMed=26589293; DOI=10.1186/s13073-015-0240-5
Scholtalbers J., Boegel S., Bukur T., Byl M., Goerges S., Sorn P., Loewer M., Sahin U., Castle J.C.
TCLP: an online cancer cell line catalogue integrating HLA type, predicted neo-epitopes, virus and gene expression.
Genome Med. 7:118.1-118.7(2015)
PubMed=27397505; DOI=10.1016/j.cell.2016.06.017
Iorio F., Knijnenburg T.A., Vis D.J., Bignell G.R., Menden M.P., Schubert M., Aben N., Goncalves E., Barthorpe S., Lightfoot H., Cokelaer T., Greninger P., van Dyk E., Chang H., de Silva H., Heyn H., Deng X.-M., Egan R.K., Liu Q.-S., Miroenko T., Mitropoulos X., Richardson L., Wang J.-H., Zhang T.-H., Moran S., Sayols S., Soleimani M., Tamborero D., Lopez-Bigas N., Ross-Macdonald P., Esteller M., Gray N.S., Haber D.A., Stratton M.R., Benes C.H., Wessels L.F.A., Saez-Rodriguez J., McDermott U., Garnett M.J.
A landscape of pharmacogenomic interactions in cancer.
Cell 166:740-754(2016)
风险提示:丁香通仅作为第三方平台,为商家信息发布提供平台空间。用户咨询产品时请注意保护个人信息及财产安全,合理判断,谨慎选购商品,商家和用户对交易行为负责。对于医疗器械类产品,请先查证核实企业经营资质和医疗器械产品注册证情况。
文献和实验*发表【中文论文】请标注:由上海盖宁生物科技有限公司提供;
*发表【英文论文】请标注:From Shanghai Gaining Biotechnology Co., Ltd.